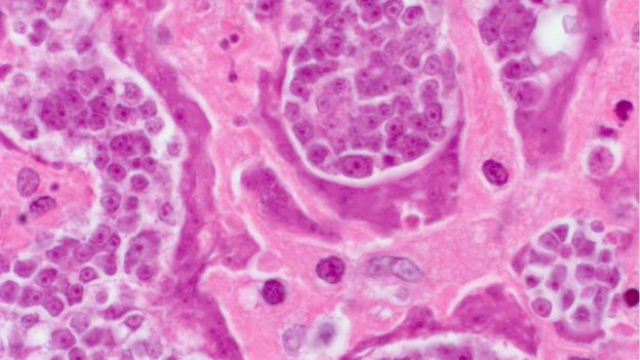

Медики и исследователи сообщили о необычном и беспрецедентном случае: солитёр, поразивший жителя Колумбии, распространил по его организму клетки злокачественной опухоли, которые в итоге привели к смерти слишком поздно обратившегося за медицинской помощью пациента.
"Мы увидели странный пример, когда инородный организм развивался в теле человека подобно опухоли ", – рассказывает паразитолог Питер Олсон (Peter Olson) из Музея естествознания в Лондоне.
Раковые клетки в теле человека впервые были выявлены в 2013 году специалистами Центра по контролю и профилактике заболеваний США у 41-летнего пациента с ВИЧ. Мужчина болел в течение нескольких месяцев и не принимал никаких лекарств. Он обратился за медицинской помощью лишь в январе 2013 года. Колумбийские врачи обнаружили, что из-за ослабленной иммунной системы он был инфицирован карликовым цепнем (Hymenolepsi nana) – достаточно распространённым паразитом, от которого страдает примерно 75 миллионов человек.
На лёгких, печени и лимфатических узлах колумбийца образовались маленькие опухоли-полипы (некоторые достигали четырёх сантиметров в диаметре). Образцы тканей были отправлены на анализ в США.
Исследование под микроскопом показало, что эти образцы оказались небольшими клетками неправильной формы, похожими на клетки злокачественной опухоли, которые, по всей видимости, поразили находящиеся рядом здоровые ткани. Клетки при этом не содержали белки человека.
Всё это выглядит очень странно. Так, учёные из США знали, что у пациента паразитарная инфекция, но по всем собранным данным нельзя сделать вывод, что внедрившиеся в организм человека клетки принадлежат сложному многоклеточному организму.
Исследователи признали, что клетки эти одновременно наводят на мысль и об инфекции, и об онкологии. По размеру данные клетки примерно в 10 раз превышали раковые клетки человека.
В мае 2013 года пациент скончался после отказа почек. Команда во главе с патологоанатомом Атисом Муэленбахсом (Atis Muehlenbachs) изучила ДНК клеток и определила, что они всё же принадлежат червю солитёру. Секвенирование генома показало, что гены клеток солитёра приобрели определённые мутации, которые в клетках человека связаны с процессами развития опухолей.
Солитёр становится причиной возникновения опухолей крайне редко, отмечают учёные. Однако Олсон лично документировал несколько других подобных случаев у больных, чья иммунная система была ослаблена.
Паразитолог полагает, что опухолевые клетки – это личинки солитёра, которые попадают из желудка в лимфатические узлы людей с ослабленным иммунитетом (здоровая иммунная система способна противостоять такому вторжению).
Далее в личинки каким-то образом попадают стволовые клетки человека. В результате вместо превращения во взрослого солитёра клетки личинки начинают делиться и расти. Эти стволовые клетки находятся в неправильном месте и получают неверные сигналы от окружающей среды, а потому и действуют по испорченной "программе", пишут учёные.
Эксперты считают, что данный случай уникален. Учёные опасаются, что пролиферативные клетки других паразитов также могут оказаться заразными, особенно учитывая тот факт, что миллионы людей сегодня страдают от ослабления иммунитета.
Случай с пациентом из Колумбии, вероятно, привёл к обнаружению нового типа патологического процесса, ранее упущенного наукой. Как известно, заразные типы рака распространяются среди животных: например, среди собак и тасманийских дьяволов.
По итогам данного открытия учёные напоминают, что не стоит пренебрегать методами, способными оградить человека от паразитов. И в современном мире лучше мыть руки с мылом и тёплой водой, тщательно мыть и термически обрабатывать сырые овощи и фрукты перед едой.
В настоящее время специалисты не могут сказать, может ли противораковая терапия как-то повлиять на такие необычные случаи.
Описание заражения и развития злокачественных клеток было опубликовано изданием New England Journal of Medicine.








